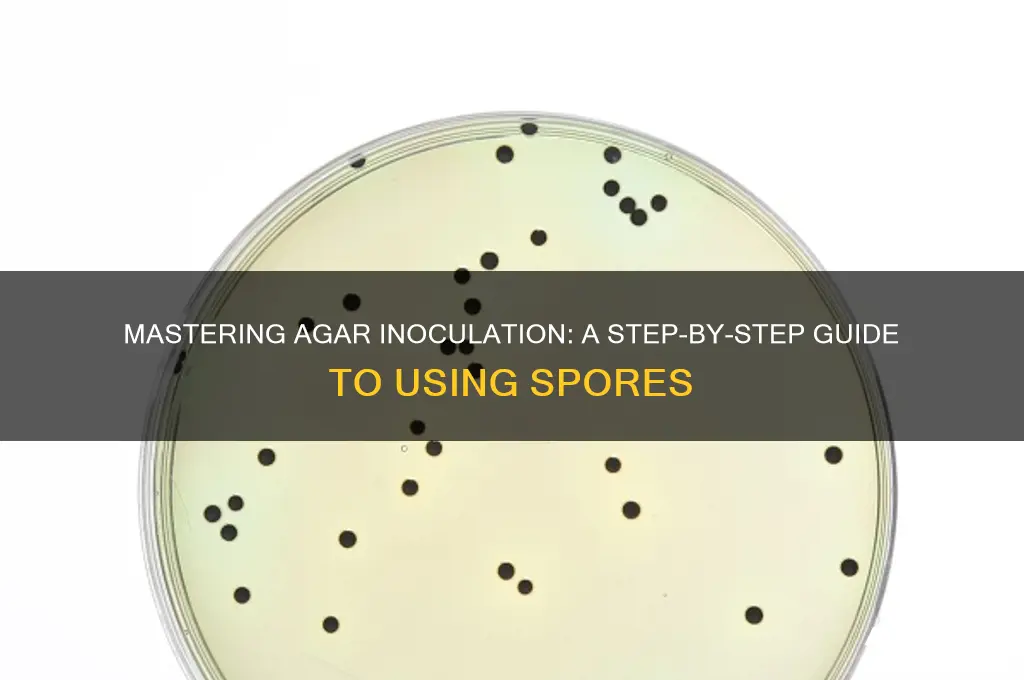
how to inoculate agar with spores

Inoculating agar with spores is a fundamental technique in microbiology used to cultivate and study microorganisms, particularly fungi and bacteria. The process involves transferring spores onto a nutrient-rich agar surface, providing an environment conducive to growth and colony formation. To begin, the agar medium must be sterilized to eliminate any competing organisms, ensuring that only the introduced spores grow. Using a sterile technique, a small sample of spores is carefully deposited onto the agar surface, often with the aid of a sterile loop or swab. The plate is then incubated under controlled conditions, such as specific temperature and humidity, to encourage spore germination and subsequent colony development. Proper aseptic technique is critical to prevent contamination and ensure accurate results. This method is widely used in research, diagnostics, and industrial applications to isolate, identify, and study microbial species.
| Characteristics | Values |
|---|---|
| Sterile Technique | Essential throughout the process to prevent contamination. Work in a laminar flow hood or sterile environment. |
| Agar Medium | Use a suitable agar medium for the specific spore type (e.g., nutrient agar, potato dextrose agar). Autoclave to sterilize. |
| Spore Suspension | Prepare a sterile spore suspension in a suitable diluent (e.g., sterile water, saline). Adjust concentration if needed. |
| Inoculation Loop/Needle | Use a sterile inoculation loop or needle to transfer spores. Flame-sterilize before and after each use. |
| Inoculation Method | Streak Plate Method: Streak the loop/needle across the agar surface in a zigzag pattern, creating zones of isolation. Pour Plate Method: Mix spore suspension with molten agar, then pour into plates and allow to solidify. |
| Incubation | Incubate plates at the optimal temperature for spore germination and growth (varies depending on spore type). |
| Incubation Time | Incubate for 24-48 hours or until visible colonies appear. |
| Colony Observation | Observe colony morphology (size, shape, color, texture) to identify different spore types. |
| Safety Precautions | Wear appropriate personal protective equipment (PPE) (e.g., lab coat, gloves, goggles). Handle spores with caution, especially if pathogenic. |
| Disposal | Autoclave all used materials, including plates and inoculation tools, before disposal. |
What You'll Learn
- Sterilize equipment to prevent contamination during the inoculation process
- Prepare spore suspension using sterile water and vortex mixing
- Use aseptic technique to transfer spores onto agar plates
- Incubate plates at optimal temperature for spore germination and growth
- Verify inoculation success by checking for visible colony formation

Sterilize equipment to prevent contamination during the inoculation process
Contamination is the arch-nemesis of any inoculation process, capable of rendering your entire experiment futile. Sterilizing equipment is your first and most critical line of defense. Every piece of equipment that comes into contact with the agar or spores—from Petri dishes to inoculation loops—must be treated as a potential vector for unwanted microorganisms. Even a single overlooked contaminant can outcompete your target spores, skewing results or halting growth altogether.
Steps for Effective Sterilization:
- Autoclaving: The gold standard for sterilizing glassware, metal tools, and culture media. Subject items to 121°C (250°F) and 15 psi for 15–20 minutes. Ensure proper loading to allow steam penetration; avoid overcrowding.
- Flaming: Ideal for inoculation loops and needles. Pass the tool through a Bunsen burner flame until it glows red, then allow it to cool momentarily before use. This method provides instant sterilization but is unsuitable for heat-sensitive materials.
- Chemical Disinfection: Use 70% ethanol or isopropanol for surfaces and equipment that cannot withstand heat. Wipe down workspaces and allow to air-dry before use. For more robust disinfection, immerse tools in a 10% bleach solution for 10 minutes, followed by thorough rinsing with sterile water.
Cautions and Considerations:
- Heat-Sensitive Materials: Plasticware or certain adhesives may warp or degrade under autoclaving conditions. Opt for chemical disinfection or disposable alternatives in such cases.
- Residue Risks: Ensure no chemical residues remain after disinfection, as these can inhibit spore germination. Rinse thoroughly with sterile water or use sterile wipes.
- Timing Matters: Sterilize equipment immediately before use to minimize exposure to airborne contaminants. Store sterilized items in a closed, clean container until needed.
Practical Tips for Success:
- Label sterilized and non-sterilized equipment clearly to avoid cross-contamination.
- Use a dedicated workspace with a laminar flow hood to maintain a sterile environment during inoculation.
- Regularly inspect autoclave tapes or indicators to confirm the sterilization cycle was effective.
By treating sterilization as a non-negotiable step, you safeguard the integrity of your inoculation process. Each method has its strengths and limitations, so tailor your approach to the equipment and conditions at hand. A meticulous sterilization protocol is the foundation upon which successful spore inoculation is built.
Ascomycota Spore Production: Unveiling the Fascinating Fungal Reproduction Process
You may want to see also

Prepare spore suspension using sterile water and vortex mixing
Sterile water serves as the ideal medium for preparing a spore suspension due to its purity and lack of contaminants that could interfere with spore viability or growth. Unlike distilled water, sterile water is free from microorganisms and particulate matter, ensuring that the suspension remains uncontaminated during the inoculation process. This step is critical when working with agar plates, as even minor impurities can compromise experimental results. Always use certified sterile water from a reliable source, and verify its sterility before use.
To create a spore suspension, begin by transferring a measured volume of sterile water (typically 1–5 mL, depending on the desired spore concentration) into a sterile tube or container. Next, introduce a small quantity of spores—either from a spore vial or a spore-bearing surface—into the water. The exact amount of spores depends on the experiment’s requirements, but a common starting point is 10^6 to 10^8 spores per mL. Gently mix the solution to ensure even distribution, but avoid vigorous agitation at this stage, as it may damage the spores.
Vortex mixing emerges as the preferred method for achieving a homogeneous spore suspension. Unlike manual shaking or pipetting, vortexing applies consistent, controlled force to disperse spores evenly throughout the liquid. Set the vortex mixer to a moderate speed (e.g., 2000–2500 rpm) to avoid shearing the spores while ensuring thorough mixing. Mix for 10–15 seconds, then allow the suspension to settle for a minute to prevent air bubbles from forming. This technique maximizes spore viability and ensures uniform inoculation across agar plates.
Practical tips can enhance the efficiency of this process. Pre-chill the sterile water to 4°C to minimize spore germination during preparation, especially if working with heat-sensitive species. Use a sterile spatula or inoculation loop to transfer spores, and flame the tool before and after use to prevent cross-contamination. If the spore source is a solid medium, gently scrape the surface to collect spores without disturbing the underlying material. Finally, label the suspension with the date, spore source, and concentration for traceability and consistency in future experiments.
In conclusion, preparing a spore suspension using sterile water and vortex mixing is a precise, reproducible technique essential for successful agar inoculation. By adhering to specific volumes, mixing protocols, and sterility practices, researchers can ensure that spores remain viable and evenly distributed. This method not only simplifies the inoculation process but also lays the foundation for accurate, reliable results in microbiological studies. Mastery of this technique is indispensable for anyone working with spore-based experiments.
Cell Division's Role in Spore Formation: A Microscopic Journey
You may want to see also

Use aseptic technique to transfer spores onto agar plates
Aseptic technique is the cornerstone of successful spore inoculation onto agar plates, ensuring that the only microorganisms present are the ones you intend to cultivate. This precision is critical in microbiology, where contamination can render experiments invalid. The process begins with a sterile environment, typically achieved through the use of a laminar flow hood or biosafety cabinet, which filters particulate matter and creates a unidirectional airflow to minimize contamination. Before handling any materials, all equipment—including inoculation loops, pipettes, and agar plates—must be sterilized, often through autoclaving at 121°C and 15 psi for at least 15 minutes. Personal protective equipment, such as lab coats, gloves, and sometimes face masks, further reduces the risk of introducing unwanted microbes.
The transfer of spores requires meticulous attention to detail. Start by flame-sterilizing the inoculation loop or needle until it glows red, ensuring all microorganisms are destroyed. Allow the loop to cool briefly to prevent killing the spores upon contact. Using a sterile technique, open the spore suspension container within the laminar flow hood, minimizing exposure to the environment. Dip the inoculated loop into the spore suspension, taking care not to contaminate the suspension itself. For precise quantification, dilutions of the spore suspension can be prepared, with common dilutions ranging from 10^-1 to 10^-6, depending on the desired colony density. Streak the loop across the agar surface in a predefined pattern, such as the quadrant or "Z" method, to achieve isolated colonies for further analysis.
One practical tip is to label agar plates before inoculation to avoid handling them afterward, reducing the risk of contamination. Additionally, maintaining a consistent temperature for the agar plates, typically around 37°C for most bacterial cultures, ensures optimal growth conditions. For spore-forming organisms like *Bacillus* or *Clostridium*, specific media such as nutrient agar or spore-specific formulations may be required. Always work quickly but deliberately, as prolonged exposure of open plates increases the likelihood of contamination.
Comparatively, aseptic technique in spore inoculation differs from other microbiological procedures in its emphasis on preventing contamination rather than merely controlling it. While techniques like subculturing or Gram staining focus on handling existing cultures, spore inoculation demands a pristine starting point. This distinction highlights the importance of sterile technique in ensuring that the agar plate serves as a blank canvas for microbial growth, uncontaminated by extraneous organisms. Mastery of this technique not only enhances experimental accuracy but also fosters confidence in the reliability of results.
In conclusion, the use of aseptic technique to transfer spores onto agar plates is a meticulous process that demands precision, preparation, and practice. From the sterilization of equipment to the careful handling of spore suspensions, each step plays a vital role in achieving uncontaminated cultures. By adhering to these principles, researchers can ensure that their agar plates provide a reliable foundation for studying microbial growth, behavior, and characteristics. Whether in academic research, industrial applications, or clinical diagnostics, this technique remains an indispensable skill in the microbiologist’s toolkit.
From Barracks to Beliefs: Can Military Cities Transform into Religious Hubs?
You may want to see also

Incubate plates at optimal temperature for spore germination and growth
After inoculating agar plates with spores, the next critical step is incubation at the optimal temperature to ensure successful germination and growth. This phase is where the dormant spores awaken and begin to develop into visible colonies. The temperature range for incubation varies depending on the spore species, but most mesophilic organisms thrive between 25°C and 37°C. For example, *Bacillus subtilis* spores typically germinate optimally at 30°C, while *Aspergillus* species may require slightly higher temperatures around 37°C. Understanding the specific requirements of your target organism is essential to avoid suboptimal growth or failure.
Incubation conditions must be carefully controlled to mimic the natural environment in which the spores would germinate. Humidity levels, for instance, should be maintained to prevent desiccation of the agar surface, which can inhibit spore germination. A common practice is to place a shallow layer of water in the bottom of the incubator or use humidity-controlled chambers. Additionally, the incubation period varies—some spores may germinate within 24 hours, while others require up to 72 hours. Regular monitoring of the plates during this period is crucial to observe early signs of growth and adjust conditions if necessary.
One often overlooked aspect of incubation is the orientation of the plates. Inverted plate placement (agar side up) is recommended to minimize condensation on the agar surface, which can disrupt colony formation. This simple adjustment can significantly improve the clarity and uniformity of the resulting colonies. For thermophilic spores, such as those from *Geobacillus* species, incubation temperatures may need to reach 50°C to 60°C, requiring specialized incubators capable of maintaining such high temperatures without drying out the agar.
While temperature is the primary focus, other factors like light exposure and air circulation can also influence spore germination. Some spores, such as those from certain fungal species, may require exposure to light to trigger germination. In contrast, others may be light-sensitive and require incubation in darkness. Ensuring proper air circulation within the incubator prevents the buildup of CO2 or other gases that could inhibit growth. By meticulously controlling these variables, researchers can create an environment that maximizes the potential for spore germination and colony development.
In conclusion, incubating agar plates at the optimal temperature is a delicate balance of science and precision. It requires not only knowledge of the spore’s specific needs but also attention to environmental factors that can subtly influence outcomes. Whether working with mesophilic, thermophilic, or light-dependent spores, the goal remains the same: to provide conditions that encourage robust and consistent growth. Mastery of this step transforms a simple inoculation into a reliable method for studying microbial life.
Can You Play Spore on Nintendo Switch? Compatibility Explained
You may want to see also

Verify inoculation success by checking for visible colony formation
Visible colony formation is the gold standard for confirming successful inoculation of agar with spores. After incubation, inspect the plate under appropriate lighting—natural daylight or a sterile hood lamp—to detect discrete, circular growths. These colonies should appear within 24 to 72 hours for most bacterial species, though fungal spores may require 5 to 7 days. If no colonies are present after the expected timeframe, recheck the incubation conditions (temperature, humidity, and duration) to ensure they align with the organism’s requirements. For example, *Bacillus subtilis* typically forms visible colonies within 24 hours at 37°C, while *Aspergillus niger* may take up to 5 days at 25°C.
Analyzing colony morphology provides additional verification of inoculation success. Healthy colonies should exhibit consistent size, color, and texture, reflecting the characteristics of the target organism. For instance, *Escherichia coli* colonies are typically smooth and off-white, while *Staphylococcus aureus* colonies may appear golden-yellow due to pigment production. Irregular or contaminated colonies—those with unusual colors, textures, or spreading patterns—suggest issues with the inoculation process, such as improper sterilization or cross-contamination. Documenting these observations with photographs or notes can aid in troubleshooting and future experimentation.
To maximize the likelihood of visible colony formation, ensure proper spore concentration during inoculation. A common method involves diluting spore suspensions to achieve 10^6 to 10^8 spores per milliliter, then applying 100 μL to the agar surface using a sterile pipette or spreader. For heat-resistant spores, such as those of *Clostridium* species, a brief heat shock at 80°C for 10 minutes prior to plating can enhance germination rates. After inoculation, allow the agar surface to dry for 10–15 minutes in a biosafety cabinet to prevent runoff and ensure even distribution of spores.
Comparing inoculated plates to negative controls is essential for interpreting results accurately. Include an uninoculated agar plate incubated under identical conditions to rule out contamination from the environment or media. If the control plate remains sterile while the inoculated plate shows colonies, success is confirmed. However, if both plates exhibit growth, revisit the sterilization procedures for equipment, media, and workspace. For added confidence, perform replicate inoculations (e.g., three plates per sample) to account for variability in spore distribution or germination efficiency.
Finally, consider the practical implications of colony visibility in real-world applications. In industrial settings, such as pharmaceutical or food production, verifying spore inoculation ensures the reliability of fermentation processes or sterility testing. For educational labs, clear colony formation reinforces microbiological techniques for students. To enhance visibility, some researchers use selective or differential media that highlight specific colony traits, such as eosin methylene blue (EMB) agar for *E. coli* or Sabouraud agar for fungi. By mastering this verification step, practitioners can confidently proceed to downstream analyses, such as biochemical tests or genetic studies, knowing their inoculation was successful.
Ultraviolet Light vs. Mold Spores: Effective Solution or Myth?
You may want to see also
Frequently asked questions
Inoculating agar with spores allows for the cultivation and observation of microbial growth, such as bacteria or fungi, in a controlled environment. It is commonly used in microbiology for identification, experimentation, and preservation of microorganisms.
You will need sterile agar plates, a spore suspension, a sterile inoculating loop or needle, a Bunsen burner or alcohol lamp for sterilization, and a laminar flow hood or sterile environment to prevent contamination.
Heat the inoculating loop or needle in a Bunsen burner flame until it glows red, then allow it to cool for a few seconds. This ensures the tool is sterile and ready for use without damaging the spores.
Using a sterile inoculating loop or needle, gently dip it into the spore suspension, then streak the agar surface in a zigzag pattern. Incubate the plate at the appropriate temperature to allow spore germination and microbial growth.

